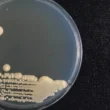

هل سمعت يومًا عن فيتامين ب2، المعروف أيضًا باسم الريبوفلافين؟ إنه ليس مجرد فيتامين عادي، بل هو لاعب أساسي في العديد من وظائف الجسم الحيوية. ينتمي هذا الفيتامين إلى عائلة فيتامينات ب الثمانية، ويتميز بكونه قابلًا للذوبان في الماء، مما يعني أن الجسم لا يخزن كميات كبيرة منه.
يمتلك الريبوفلافين دورًا محوريًا في ضمان النمو السليم للخلايا وتحسين قدرتها على أداء وظائفها بكفاءة. أي نقص في مستوياته قد يجعلك عرضة لمجموعة من المشكلات الصحية المتنوعة. لذا، من الضروري الحصول على حصة كافية منه يوميًا من خلال نظام غذائي متوازن.
في هذا المقال، نغوص في عالم فوائد فيتامين ب2 المدهشة، ونستكشف أعراض نقصه الشائعة، ونسلط الضوء على أفضل المصادر الغذائية الغنية به. استعدوا لاكتشاف كيف يمكن لهذا الفيتامين أن يدعم صحتكم من الرأس حتى أخمص القدمين!
جدول المحتويات
- ما هو فيتامين ب2 (الريبوفلافين)؟
- فوائد فيتامين ب2 المذهلة لجسمك
- مؤشرات نقص فيتامين ب2: الأعراض الشائعة
- أفضل المصادر الغذائية لفيتامين ب2
- الخلاصة
ما هو فيتامين ب2 (الريبوفلافين)؟
فيتامين ب2، أو الريبوفلافين، هو أحد الفيتامينات الثمانية التي تشكل عائلة فيتامينات ب المعقدة. يتميز هذا الفيتامين بكونه قابلًا للذوبان في الماء، مما يعني أن الجسم يمتصه مع السوائل الزائدة ويمكنه التخلص من أي كمية إضافية عبر البول.
يلعب الريبوفلافين دورًا حيويًا في العديد من العمليات الخلوية، خاصة في إنتاج الطاقة. إنه ضروري لتحويل الطعام الذي نتناوله إلى طاقة قابلة للاستخدام، ويدعم وظائف الإنزيمات الرئيسية في الجسم. نظرًا لأن الجسم لا يستطيع تخزين كميات كبيرة من فيتامين ب2، فإن الحصول عليه بانتظام من المصادر الغذائية أمر بالغ الأهمية للحفاظ على مستوياته المثلى.
فوائد فيتامين ب2 المذهلة لجسمك
يساهم فيتامين ب2 في دعم عدد لا يحصى من الوظائف الحيوية، مما يجعله عنصرًا غذائيًا لا غنى عنه. إليك أبرز فوائد فيتامين ب2 التي تدعم صحتك العامة:
حماية الخلايا ومكافحة السرطان
قد يساعد فيتامين ب2 في حماية خلايا الجسم من التلف. يعود ذلك غالبًا إلى قدرته على حماية الحمض النووي (DNA) في الخلايا من التلف الذي قد تحدثه العوامل المحفزة للأمراض، مثل بعض المواد الكيميائية. من خلال إضفاء نوع من الاستقرار على بنية الخلية وحمضها النووي، يساهم الريبوفلافين في منع التكاثر غير المنضبط للخلايا، مما قد يقلل بدوره من خطر الإصابة ببعض أنواع السرطان.
تخفيف نوبات الشقيقة
يلعب فيتامين ب2 دورًا مهمًا في علاج ومحاربة الصداع النصفي (الشقيقة). أظهرت الدراسات أن تناول جرعات معينة من مكملات فيتامين ب2 قد يكون فعالًا في تقليل عدد نوبات الشقيقة التي تصيب المرضى شهريًا. كما أن تناوله مع بعض المعادن قد يساعد في تخفيف حدة الألم خلال النوبة.
الحفاظ على صحة العيون
يساهم تناول جرعات كافية من فيتامين ب2 يوميًا في الحفاظ على صحة العيون وحمايتها من الأمراض. قد يقلل هذا الفيتامين من فرص الإصابة بإعتام عدسة العين (الماء الأبيض)، ومرض الزرق (الغلوكوما)، ومرض القرنية المخروطية. وقد لوحظ أن مزيجًا من فيتامين ب2 والنياسين قد يمنع الإصابة بإعتام عدسة العين.
دعم الجهاز العصبي
يساعد فيتامين ب2 في تخفيف الأعراض المزعجة المصاحبة لبعض أمراض الجهاز العصبي ومشاكله، مثل التنميل والخدر والقلق. يعتقد الباحثون أن تناول جرعات من فيتامين ب2 مع فيتامين ب6 قد يساهم في التخفيف من الأعراض الشديدة لمتلازمة النفق الرسغي.
تنظيم مستويات الهوموسيستين
يرفع ارتفاع مستويات حمض الهوموسيستين الأميني في الدم (Homocysteinemia) من فرص الإصابة بمشاكل صحية خطيرة، مثل النوبة القلبية والسكتة الدماغية والخرف. يعد خفض مستويات الهوموسيستين أمرًا بالغ الأهمية، وهنا يأتي دور فيتامين ب2. فقد أظهرت الدراسات أن مكملات فيتامين ب2 قد تساهم في خفض مستويات الهوموسيستين بنسبة تصل إلى 40%.
فوائد أخرى شاملة
تتعدد فوائد فيتامين ب2 للجسم ولا تقتصر على ما ذكرناه فحسب، بل تمتد لتشمل الآتي:
- تعزيز عمليات الأيض في الجسم، مثل تحطيم الدهون والكربوهيدرات لتوفير الطاقة اللازمة.
- محاربة وعلاج فقر الدم (الأنيميا).
- ضمان النمو السليم للجنين أثناء الحمل.
- خفض ضغط الدم المرتفع.
- تخفيف حدة التشنجات العضلية.
- خفض فرص الإصابة بأمراض القلب وجهاز الدوران.
- الحفاظ على صحة الكبد ووظائفه.
- تحسين قدرة الجسم على امتصاص العناصر الغذائية والاستفادة منها، مثل حمض الفوليك وفيتامين ب1 وب3 وب6.
- تعزيز عملية استقلاب الأدوية في الكبد.
- تعزيز صحة الجلد والبشرة، ومنحها نضارة وحيوية.
- مساعدة الغدة الكظرية على إنتاج هرموناتها المختلفة.
مؤشرات نقص فيتامين ب2: الأعراض الشائعة
عندما لا يحصل الجسم على كمية كافية من فيتامين ب2، قد تظهر مجموعة من الأعراض التي تشير إلى هذا النقص. من المهم التعرف على هذه المؤشرات لطلب المشورة الطبية إذا لزم الأمر. إليك أبرز الأعراض الشائعة لنقص فيتامين ب2:
- فقر الدم: يؤثر النقص على إنتاج خلايا الدم الحمراء.
- مشكلات في عمليات الأيض: ضعف في قدرة الجسم على تحويل الطعام إلى طاقة.
- التهاب الحلق أو الفم أو اللسان: قد تظهر تقرحات أو احمرار.
- انتفاخ وتورم في الأنسجة المخاطية: خاصة في الفم والحلق.
- تعب وإرهاق: شعور عام بالإعياء وقلة الطاقة.
- تشققات في الفم أو الشفتين: غالبًا في زوايا الفم (التهاب الشفة الزاوي).
- التهابات ومشاكل جلدية: خاصة حول الأنف والوجه.
- مشكلات عصبية: مثل التنميل أو الخدر.
- تقلبات مزاجية: قد يؤثر النقص على الصحة النفسية.
أفضل المصادر الغذائية لفيتامين ب2
لحسن الحظ، يتوفر فيتامين ب2 في مجموعة واسعة من الأطعمة اليومية، مما يسهل الحصول على الكمية الموصى بها. إليك قائمة بأهم المصادر الطبيعية الغنية بالريبوفلافين:
- منتجات الحليب والألبان، مثل الحليب واللبن والجبن.
- اللحوم الحمراء والبيضاء، بما في ذلك السمك، والدجاج، واللحم البقري.
- الكبدة والأعضاء الداخلية الأخرى.
- الخضروات التي تنتمي للعائلة الصليبية، مثل القرنبيط والبروكلي.
- البيض، وهو مصدر ممتاز.
- أعشاب البحر والطحالب.
- الفطر بمختلف أنواعه.
- البقدونس.
- البطاطا الحلوة.
- المكسرات بأنواعها.
- الأرضي شوكي.
- الأفوكادو.
- الهليون.
- السبانخ والخضروات الورقية الخضراء الداكنة.
- الفول.
- دبس السكر (العسل الأسود).
- المنتجات المصنوعة من الحبوب الكاملة.
الخلاصة
فيتامين ب2، أو الريبوفلافين، هو عنصر غذائي حيوي يلعب أدوارًا لا غنى عنها في دعم صحة الجسم العامة، من تعزيز مستويات الطاقة وحماية الخلايا إلى دعم الجهاز العصبي والعيون. إن فهم فوائد فيتامين ب2 ومصادره الغنية يساعدنا على اتخاذ خيارات غذائية ذكية.
تذكروا أن الحفاظ على نظام غذائي متوازن وغني بهذه المصادر الطبيعية هو المفتاح لتجنب نقص الريبوفلافين والاستمتاع بجميع فوائده الصحية. دمج هذه الأطعمة في وجباتكم اليومية يضمن لكم الحصول على هذا الفيتامين الهام بانتظام.